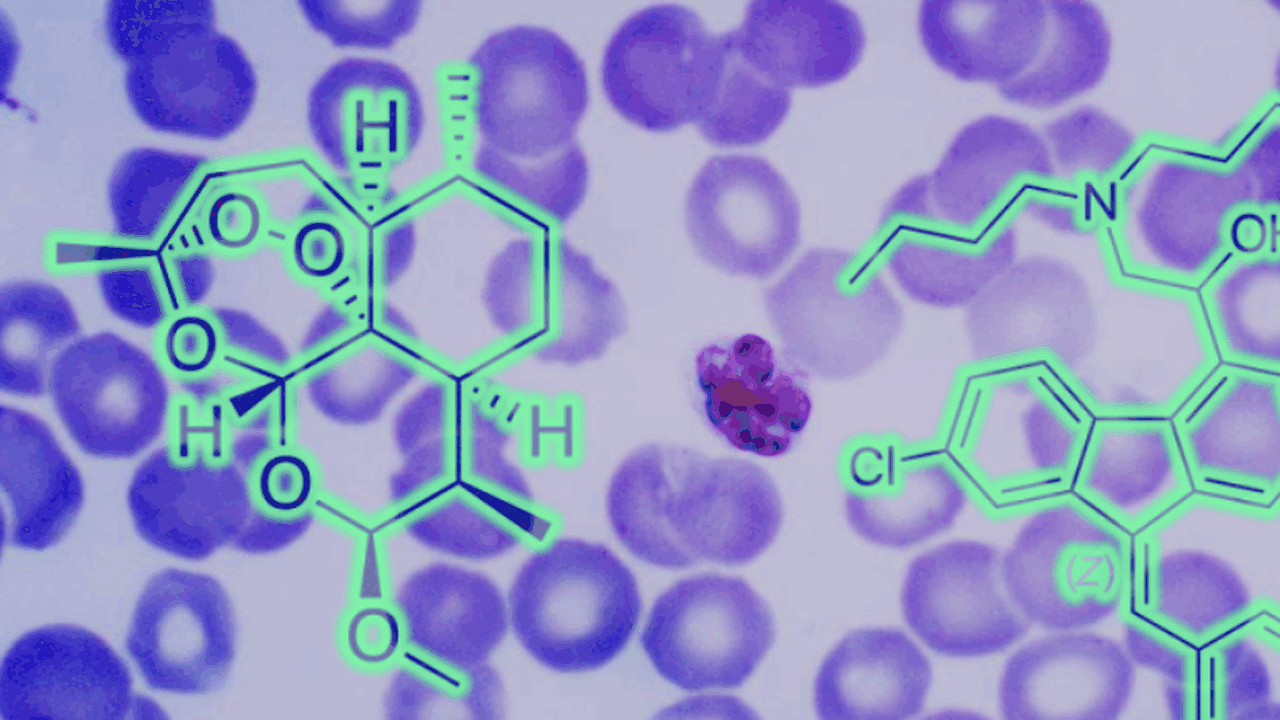
Всемирная организация здравоохранения провела п...

ВОЗ одобрила первый препарат от малярии для новорождённых и младенцев
Wikimedia Commons / Public Domain
Всемирная организация здравоохранения провела преквалификацию первого лекарственного средства для лечения малярии, предназначенного для новорождённых и детей раннего возраста с массой тела от 2 до 5 килограммов. Препарат основан на фиксированной комбинации артеметера и люмефантрина.
До появления этой формы терапии младенцев лечили препаратами, рассчитанными на более старшие возрастные группы. Это создавало сложности с точным дозированием и повышало риск нежелательных побочных эффектов и токсических реакций.
Преквалификация ВОЗ подтверждает соответствие препарата международным требованиям к качеству, эффективности и безопасности. Такой статус позволяет государственным системам здравоохранения закупать лекарство для централизованного применения.
По оценкам организации, доступ к новой терапии может быть обеспечен примерно для 30 миллионов детей, ежегодно рождающихся в регионах, где малярия является эндемичным заболеванием.



